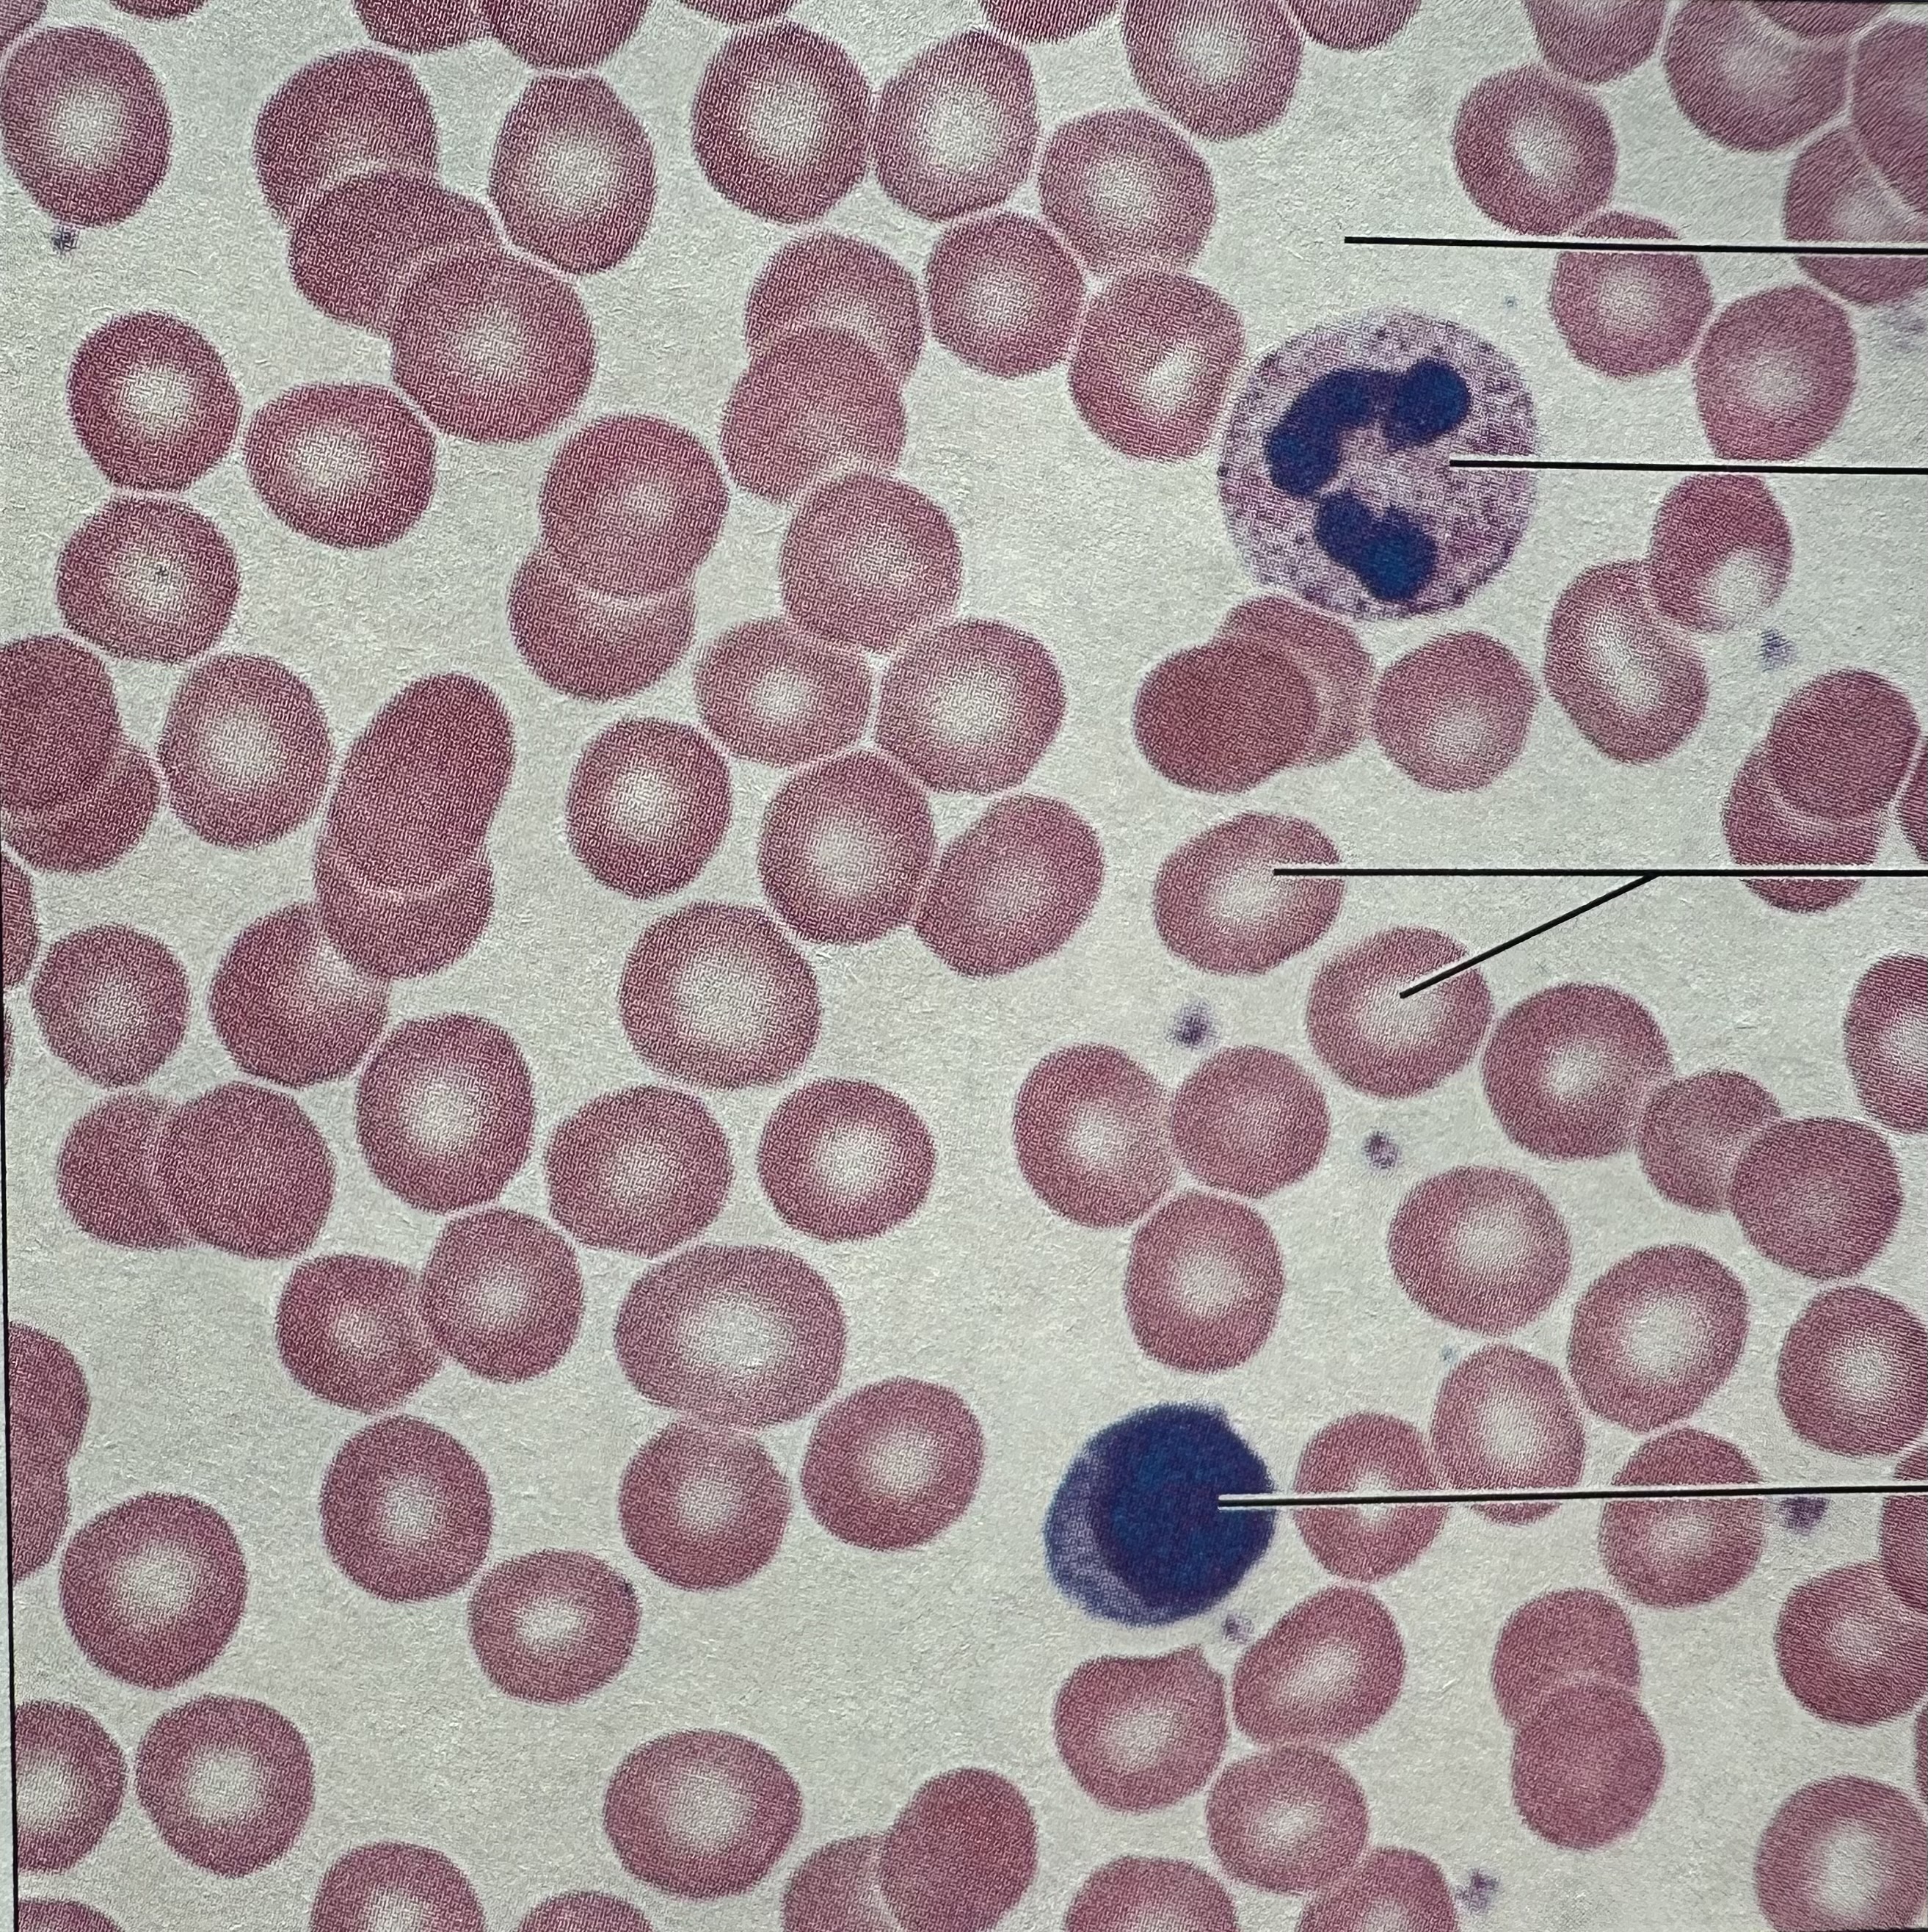

1/18
Looks like no tags are added yet.
Name | Mastery | Learn | Test | Matching | Spaced | Call with Kai |
|---|
No analytics yet
Send a link to your students to track their progress

bone connective tissue (osseous tissue)
found in bones

cardiac muscle tissue
found in walls of heart

smooth muscle tissue
found in the bladder

skeletal muscle tissue
found in skeletal muscles

loose connective tissue areolar
found under epithelial tissues

loose connective tissue adipose
found in breasts

loose connective tissue reticular
found in spleen

dense irregular connective tissue
found in dermis of skin

hyaline cartilage connective
found in costal areas of the ribs

elastic cartilage connective
found in pinna of ear
blood connective tissue
found within blood vessels

fibrocartilage connective tissue
found in intervertebral disks

simple squamous epithelium
found in lungs

simple cuboidal epithelium
found in kidneys

simple columnar epithelium
found in gut

pseudostratified ciliated columnar
found in trachea

transitional epithelium
found in ureter

neuron (nervous tissue)
found in spinal cord

dense regular connective tissue
found in tendons and ligaments